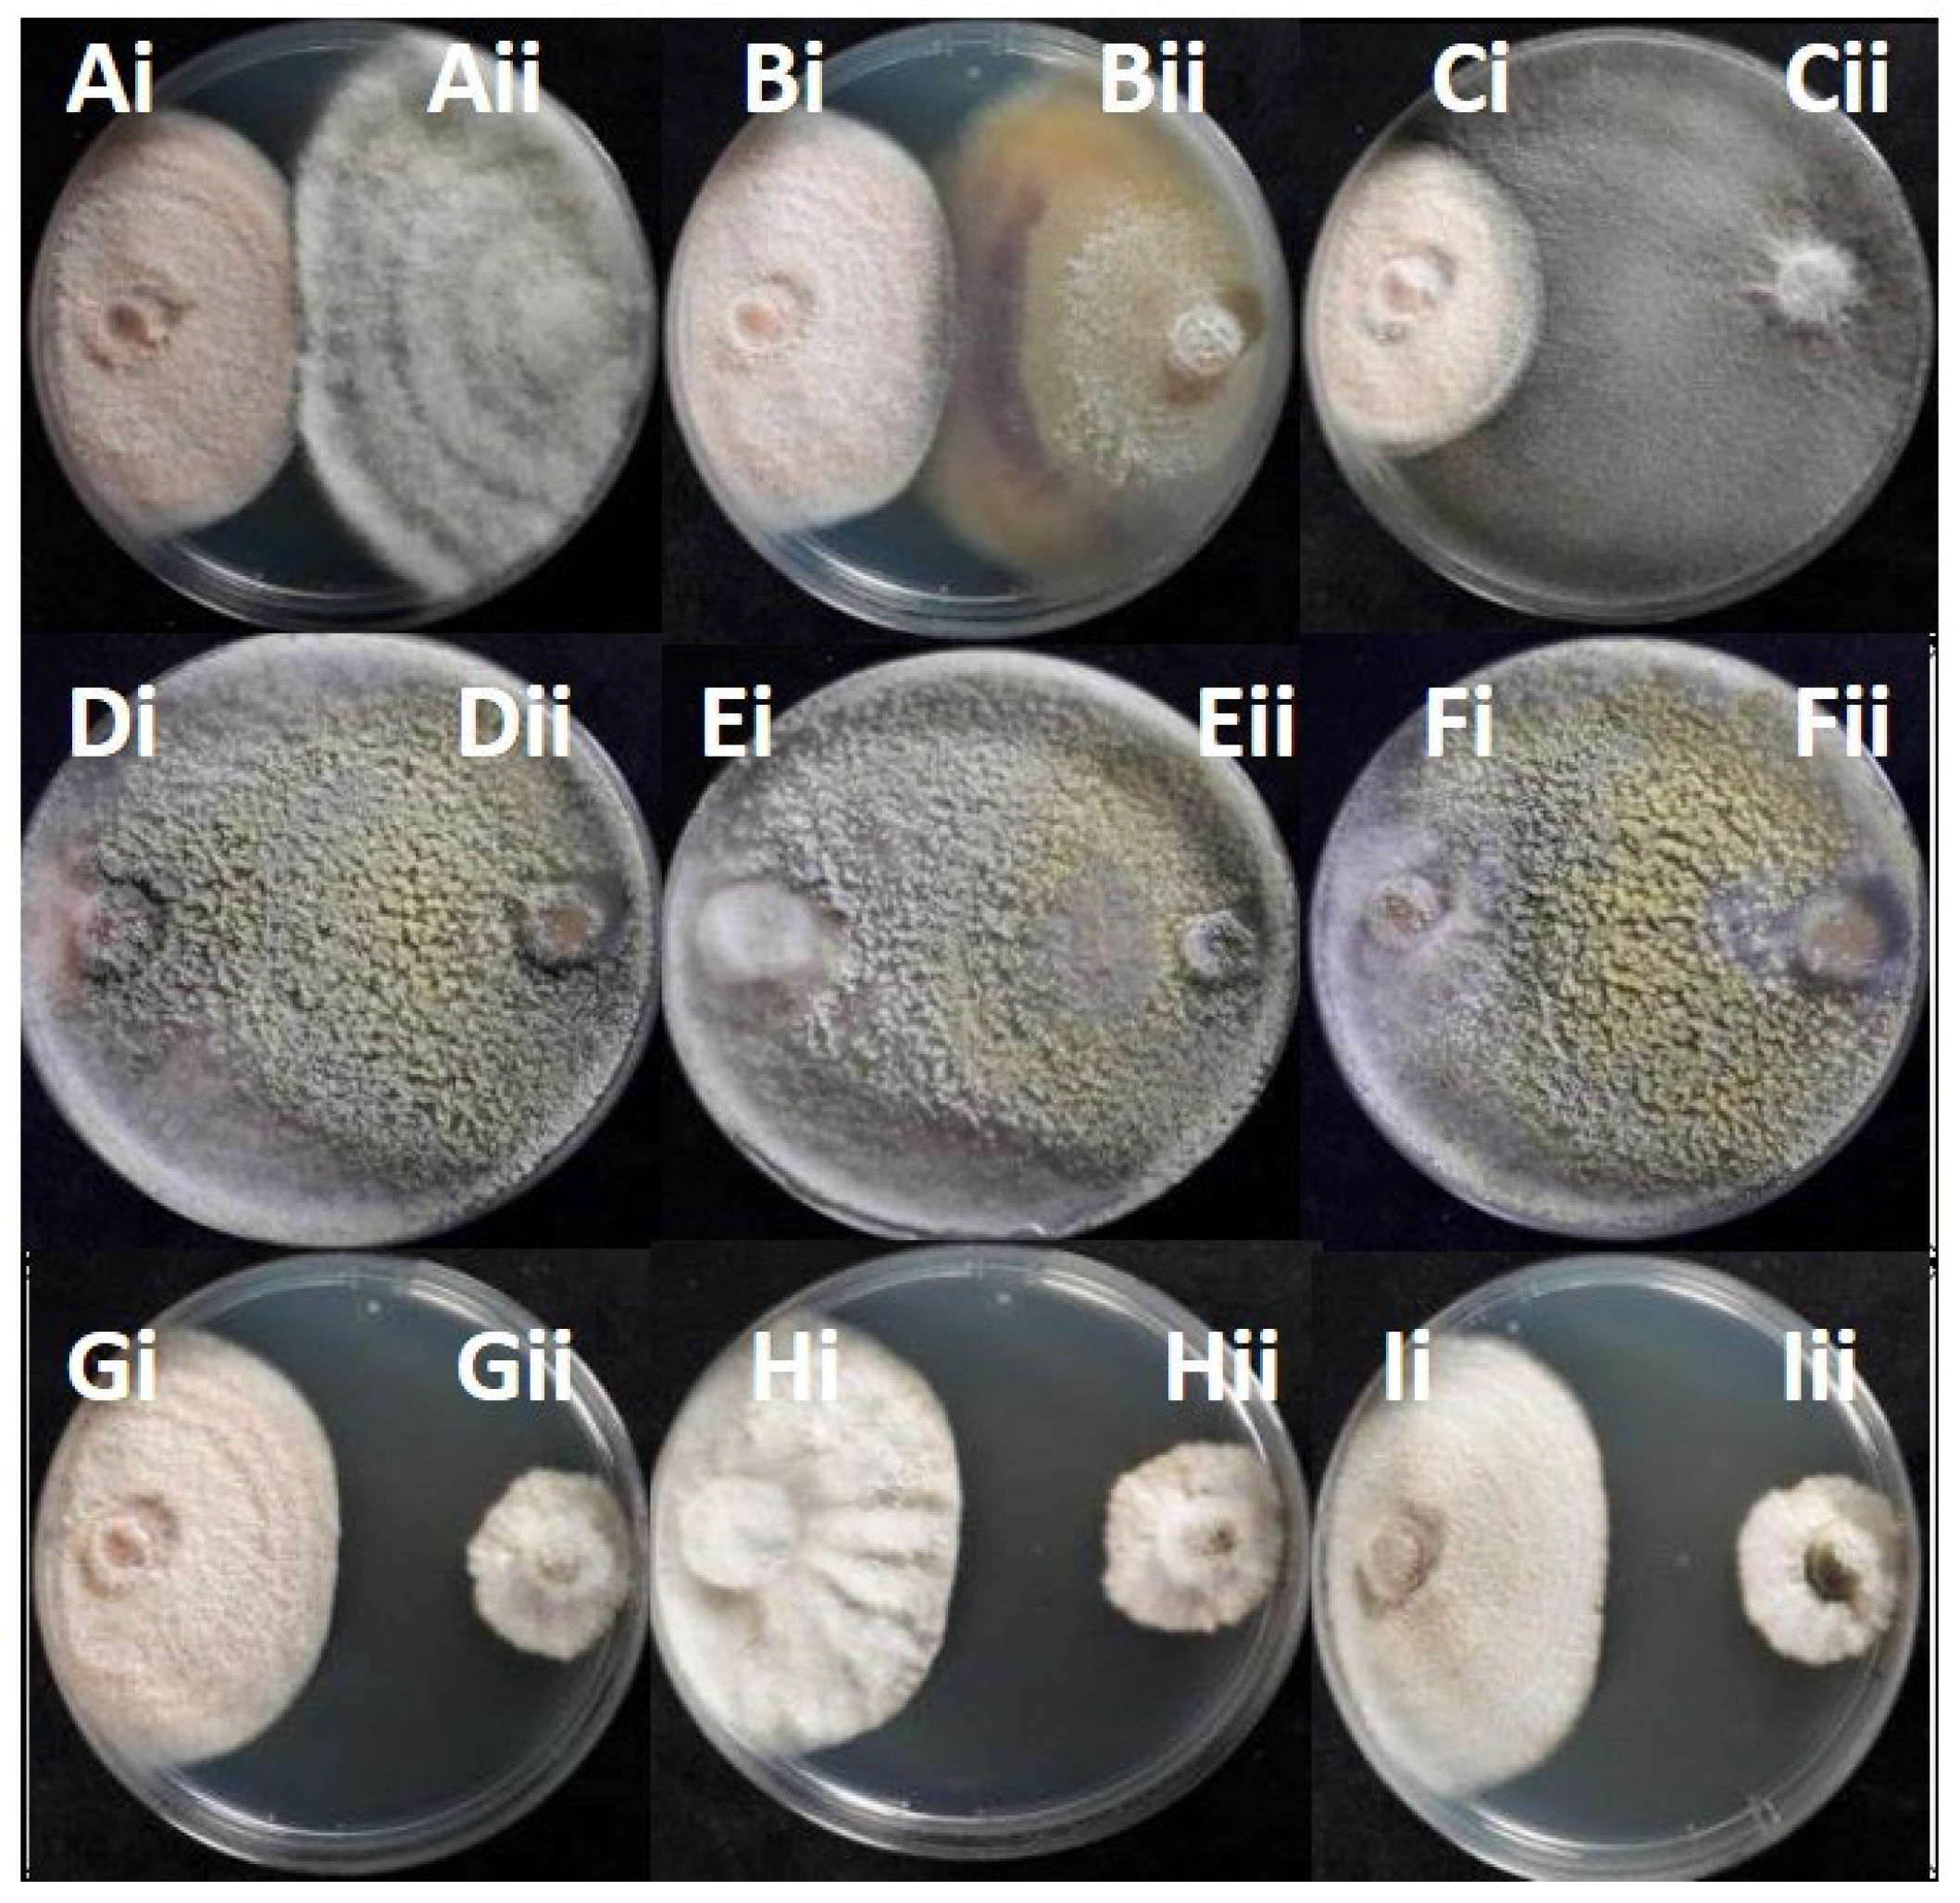
Microorganisms 13 02838 g007 Microorganisms 13 02838 g007

Colletotrichum scovillei and Prospective Biocontrol Agents Isolated from Asymptomatic Olive Trees
Abstract
1. Introduction
2. Materials and Methods
2.1. Sampling and Isolation and Identification of Fungal Endophytes
2.2. Identification of Fungal Endophytes
2.3. Virulence Testing
2.4. In Vitro Evaluation of the Antagonistic Activity of Endophytic Fungal Strains Against the Selected Colletotrichum spp.
2.5. Effect of Colletotrichum Antagonistic Fungal Strains on Anthracnose Severity
2.6. Extraction of Secreted Diffusible Antifungal Compounds
2.7. Thin-Layer Chromatography and Agar Overlay Bioautography Method
2.8. Atmospheric Examination of Olive Sampling Areas
2.9. Statistical Analysis
3. Results
3.1. Isolation and Molecular Identification of Fungi from Surface-Sterilized, Symptomless Olive Fruits and Leaves
3.2. Phylogeny of the Endophytic Colletotrichum Species and Colonial Morphology
3.3. Virulence of the Endophytic Colletotrichum on Detached Olive Fruits
3.4. In Vitro Antagonistic Potential of Endophytic Fungi Against Colletotrichum
3.5. In Planta Antagonism of Endophytic Fungi Against Pathogenic Colletotrichum
3.6. Metabolites Secreted During the Interaction Endophytic Fungi and Colletotrichum Pathogens Suppress the Growth of Fungal Pathogens
3.7. Atmospheric Conditions Differentiation as a Potential Driver of Colletotrichum Species Distribution
4. Discussion
5. Conclusions
Supplementary Materials
Author Contributions
Funding
Data Availability Statement
Conflicts of Interest
References
- da Silva, L.L.; Moreno, H.L.A.; Correia, H.L.N.; Santana, M.F.; de Queiroz, M.V. Colletotrichum: Species complexes, lifestyle, and peculiarities of some sources of genetic variability. Appl. Microbiol. Biotechnol. 2020, 104, 1891–1904. [Google Scholar] [CrossRef] [PubMed]
- Liu, F.; Ma, Z.Y.; Hou, L.W.; Diao, Y.Z.; Wu, W.P.; Damm, U.; Song, S.; Cai, L. Updating species diversity of Colletotrichum, with a phylogenomic overview. Stud Mycol. 2022, 101, 1–56. [Google Scholar] [CrossRef] [PubMed]
- Guo, J.W.; Tian, R.C.; Yang, C.L.; Jia, L.; Zhou, S.Y.; Yang, M.; Shen, S.K. The Occurrence of Colletotrichum karstii and C. fructicola Causes Anthracnose on Endangered Ethnic Vegetable Yunnanopilia longistaminea in Yunnan, China. J. Fungi 2025, 11, 748. [Google Scholar] [CrossRef] [PubMed]
- Talhinhas, P.; Baroncelli, R. Hosts of Colletotrichum. Mycosphere 2023, 14, 158–261. [Google Scholar] [CrossRef]
- Jayawardena, R.S.; Bhunjun, C.S.; Hyde, K.D.; Gentekaki, E.; Itthayakorn, P. Colletotrichum: Lifestyles, biology, morpho-species, species complexes and accepted species. Mycosphere 2021, 12, 519–699. [Google Scholar] [CrossRef]
- de Silva, D.D.; Crous, P.W.; Ades, P.K.; Hyde, K.D.; Taylor, P.W. Life styles of Colletotrichum species and implications for plant biosecurity. Fungal Biol. Rev. 2017, 31, 155–168. [Google Scholar] [CrossRef]
- Mejía, L.C.; Rojas, E.I.; Maynard, Z.; Van Bael, S.; Arnold, A.E.; Hebbar, P.; Samuels, G.J.; Robbins, N.; Herre, E.A. Endophytic fungi as biocontrol agents of Theobroma cacao pathogens. Biol. Control. 2008, 46, 4–14. [Google Scholar] [CrossRef]
- Huang, L.Q.; Niu, Y.C.; Su, L.; Deng, H.; Lyu, H. The potential of endophytic fungi isolated from cucurbit plants for biocontrol of soilborne fungal diseases of cucumber. Microbiol. Res. 2020, 231, 126369. [Google Scholar] [CrossRef]
- Hiruma, K.; Gerlach, N.; Sacristán, S.; Nakano, R.T.; Hacquard, S.; Kracher, B.; Neumann, U.; Ramírez, D.; Bucher, M.; O’Connell, R.J.; et al. Root Endophyte Colletotrichum tofieldiae confers plant fitness benefits that are phosphate status dependent. Cell 2016, 165, 464–474. [Google Scholar] [CrossRef]
- Talhinhas, P.; Loureiro, A.; Oliveira, H. Olive anthracnose: A yield-and oil quality-degrading disease caused by several species of Colletotrichum that differ in virulence, host preference and geographical distribution. Mol. Plant Pathol. 2018, 19, 1797–1807. [Google Scholar] [CrossRef]
- Xhemali, B.; Cortiello, M.; Gjinovci, G.; Bresilla, B.; Stefani, E.; Giovanardi, D. First report of Colletotrichum scovillei causing anthracnose of pepper in Kosovo. New Dis. Rep. 2023, 47, e12189. [Google Scholar] [CrossRef]
- Khatri, V.; Miller, S.A.; Rotondo, F. First report of Colletotrichum scovillei causing anthracnose fruit rot of pepper in Ohio. Plant Dis. 2024, 19, 2564. [Google Scholar] [CrossRef]
- Ellouze, W.; Lofano, A.; Tracey, A.; Goldenhar, K. First Report of Colletotrichum scovillei Causing Anthracnose Fruit Rot on Pepper in Ontario, Canada. Plant Dis. 2024, 108, 7. [Google Scholar] [CrossRef]
- Goh, K.S.; Balasubramaniam, J.; Sani, S.F.; Alam, M.W.; Ismail, N.A.; Gleason, M.L.; Rosli, H. First Report of Colletotrichum scovillei Causing Anthracnose on Watermelon (Citrullus lanatus) in Malaysia. Plant Dis. 2022, 6, 2521. [Google Scholar] [CrossRef]
- Qin, L.P.; Zhang, Y.; Su, Q.; Chen, Y.L.; Nong, Q.; Xie, L.; Yu, G.M.; Huang, S.L. First report of anthracnose of Mangifera indica caused by Colletotrichum scovillei in China. Plant Dis. 2019, 103, 1043. [Google Scholar] [CrossRef]
- Wu, J.; Wang, H.; Fang, L.; Xie, Y.; Wang, L. First report of Colletotrichum scovillei causing anthracnose fruit rot on Eriobotrya japonicain in Zhejiang province, China. Plant Dis. 2022, 22, 2752. [Google Scholar] [CrossRef]
- Chakraborty, S.; Newton, A.C. Climate change, plant diseases and food security: An overview. Plant Pathol. 2011, 60, 2–14. [Google Scholar] [CrossRef]
- Materatski, P.; Varanda, C.; Carvalho, T.; Dias, A.B.; Campos, M.D.; Rei, F.; Félix, M.d.R. Diversity of Colletotrichum Species Associated with Olive Anthracnose and New Perspectives on Controlling the Disease in Portugal. Agronomy 2018, 8, 301. [Google Scholar] [CrossRef]
- Martins, F.; Cameirão, C.; Mina, D.; Benhadi-Marín, J.; Pereira, J.A.; Baptista, P. Endophytic fungal community succession in reproductive organs of two olive tree cultivars with contrasting anthracnose susceptibilities. Fungal Ecol. 2021, 49, 101003. [Google Scholar] [CrossRef]
- Martins, F.; Mina, D.; Pereira, J.A.; Baptista, P. Endophytic fungal community structure in olive orchards with high and low incidence of olive anthracnose. Sci. Rep. 2021, 11, 689. [Google Scholar] [CrossRef]
- Schena, L.; Abdelfattah, A.; Mosca, S.; Li Destri Nicosia, M.G.; Agosteo, G.E.; Cacciola, S.O. Quantitative detection of Colletotrichum godetiae and C. acutatum sensu stricto in the phyllosphere and carposphere of olive during four phenological phases. Eur. J. Plant Pathol. 2017, 149, 337–347. [Google Scholar] [CrossRef]
- Varveri, M.; Papageorgiou, A.G.; Tsitsigiannis, D.I. Evaluation of Biological Plant Protection Products for Their Ability to Induce Olive Innate Immune Mechanisms and Control Colletotrichum acutatum, the Causal Agent of Olive Anthracnose. Plants 2024, 13, 878. [Google Scholar] [CrossRef] [PubMed]
- Prihastuti, H.; Cai, L.; Chen, H.; McKenzie, E.H.C.; Hyde, K.D. Characterization of Colletotrichum species associated with coffee berries in northern Thailand. Fungal Divers 2009, 39, 89–109. [Google Scholar]
- Waculicz-Andrade, C.E.; Savi, D.C.; Bini, A.P.; Adamoski, D.; Goulin, E.H.; Silva, G.J.; Massola, N.S., Jr.; Terasawa, L.G.; Kava, V.; Glienke, C. Colletotrichum gloeosporioides sensu stricto: An endophytic species or citrus pathogen in Brazil? Australas. Plant Pathol. 2017, 46, 191–203. [Google Scholar] [CrossRef]
- Lisboa, D.O.; Silva, M.A.; Pinho, D.B.; Pereira, O.L.; Furtado, G.Q. Diversity of pathogenic and endophytic Colletotrichum isolates from Licania tomentosa in Brazil. For. Pathol. 2018, 48, e12448. [Google Scholar] [CrossRef]
- dos Santos Oliveira, J.A.; Polli, A.D.; Polonio, J.C.; Orlandelli, R.C.; Conte, H.; Azevedo, J.L.; Pamphile, J.A. Bioprospection and molecular phylogeny of culturable endophytic fungi associated with yellow passion fruit. Acta Sci. Biol. Sci. 2020, 42, 1–11. [Google Scholar] [CrossRef]
- Peters, L.P.; Prado, L.S.; Silva, F.I.; Souza, F.S.; Carvalho, C.M. Selection of endophytes as antagonists of Colletotrichum gloeosporioides in açaí palm. Biol. Control. 2020, 150, 104350. [Google Scholar] [CrossRef]
- Delaye, L.; García-Guzmán, G.; Heil, M. Endophytes versus biotrophic and necrotrophic pathogens—Are fungal lifestyles evolutionarily stable traits? Fungal Divers 2013, 60, 125–135. [Google Scholar] [CrossRef]
- Stergiopoulos, I.; Gordon, T.R. Cryptic fungal infections: The hidden agenda of plant pathogens. Front. Plant Sci. 2014, 5, 506. [Google Scholar] [CrossRef]
- Schulz, B.; Haas, S.; Junker, C.; Andrée, N.; Schobert, M. Fungal endophytes are involved in multiple balanced antagonisms. Curr. Sci. 2005, 109, 39–45. [Google Scholar]
- Preto, G.; Martins, F.; Pereira, J.A.; Baptista, P. Fungal community in olive fruits of cultivars with different susceptibilities to anthracnose and selection of isolates to be used as biocontrol agents. Biol. Control. 2017, 110, 1–9. [Google Scholar] [CrossRef]
- Ji, X.; Xia, Y.; Zhang, H.; Cui, J.-L. The microscopic mechanism between endophytic fungi and host plants: From recognition to building stable mutually beneficial relationships. Microbiol. Res. 2022, 261, 127056. [Google Scholar] [CrossRef] [PubMed]
- George, M.E.; Gaitor, T.T.; Cluck, D.B.; Henao-Martínez, A.F.; Sells, N.R.; Chastain, D.B. The impact of climate change on the epidemiology of fungal infections: Implications for diagnosis, treatment, and public health strategies. Ther. Adv. Infect. Dis. 2025, 12, 20499361251313841. [Google Scholar] [CrossRef] [PubMed]
- Salotti, I.; Ji, T.; Rossi, V. Temperature requirements of Colletotrichum spp. belonging to different clades. Front. Plant Sci. 2022, 22, 953760. [Google Scholar] [CrossRef]
- Stefanoudaki, E.; Kotsifaki, F.; Koutsaftakis, A. Sensory and chemical profiles of three European olive varieties (Olea europaea L.): An approach for the characterisation and authentication of the extracted oils. J. Sci. Food Agric. 2000, 80, 381–389. [Google Scholar] [CrossRef]
- Kalogiouri, N.P.; Aalizadeh, R.; Dasenaki, M.E.; Thomaidis, N.S. Authentication of Greek PDO Kalamata Table Olives: A Novel Non-Target High Resolution Mass Spectrometric Approach. Molecules 2020, 25, 2919. [Google Scholar] [CrossRef]
- Iliadi, M.K.; Tjamos, E.C.; Antoniou, P.P.; Tsitsigiannis, D.I. First report of Colletotrichum acutatum causing anthracnose on olives in Greece. Plant Dis. 2018, 102, 820. [Google Scholar] [CrossRef]
- Kolainis, S.; Koletti, A.; Lykogianni, M.; Karamanou, D.; Gkizi, D.; Tjamos, S.E.; Paraskeuopoulos, A.; Aliferis, K.A. An integrated approach to improve plant protection against olive anthracnose caused by the Colletotrichum acutatum species complex. PLoS ONE 2020, 15, e0233916. [Google Scholar] [CrossRef]
- Angeli, C.; Tsalgatidou, P.C.; Tsafouros, A.; Venieraki, A.; Zambounis, A.; Vithoulkas, A.; Milionis, A.; Paplomatas, E.J.; Demopoulos, V.; Delis, C. Genetic and Phytopathogenic Characterization of Endemic Colletotrichum Isolates in Major Olive Cultivars of Greece. Horticulturae 2024, 10, 847. [Google Scholar] [CrossRef]
- Tsalgatidou, P.C.; Thomloudi, E.-E.; Nifakos, K.; Delis, C.; Venieraki, A.; Katinakis, P. Calendula officinalis—A Great Source of Plant Growth Promoting Endophytic Bacteria (PGPEB) and Biological Control Agents (BCA). Microorganisms 2023, 11, 206. [Google Scholar] [CrossRef]
- Saunders, M.; Kohn, L.M. Evidence for alteration of fungal endophyte community assembly by host defense compounds. New Phytol. 2009, 182, 229–238. [Google Scholar] [CrossRef] [PubMed]
- White, T.J.; Bruns, T.D.; Lee, S.; Taylor, J. In PCR Protocols: A Guide to Methods and Applications; Innis, M.A., Gelfand, D.H., Eds.; Amplification and direct sequencing of fungal ribosomal RNA genes for phylogenetics. Academic Press: London, UK, 1990; pp. 315–322. [Google Scholar]
- Damm, U.; Cannon, P.F.; Woudenberg, J.H.C.; Crous, P.W. The Colletotrichum acutatum species complex. Stud. Mycol. 2012, 73, 37–113. [Google Scholar] [CrossRef] [PubMed]
- Azevedo-Nogueira, F.; Gomes, S.; Lino, A.; Carvalho, T.; Martins-Lopes, P. Real-time PCR assay for Colletotrichum acutatum sensu stricto quantification in olive fruit samples. Food Chem. 2021, 339, 127858. [Google Scholar] [CrossRef] [PubMed]
- Chen, H.Q.; Cao, L.; Dekkers, K.L.; Rollins, J.A.; Ko, N.J.; Timmer, L.W.; Chung, K.R. A gene with domains related to transcription regulation is required for pathogenicity in Colletotrichum acutatum causing Key lime anthracnose. Mol Plant Pathol. 2005, 6, 513–525. [Google Scholar] [CrossRef]
- Tamura, K.; Nei, M. Estimation of the number of nucleotide substitutions in the control region of mitochondrial DNA in humans and chimpanzees. Mol. Biol. Evol. 1993, 10, 512–526. [Google Scholar] [CrossRef]
- Tamura, K.; Stecher, G.; Kumar, S. MEGA 11: Molecular Evolutionary Genetics Analysis Version 11. Mol. Biol. Evol. 2021, 38, 3022–3027. [Google Scholar] [CrossRef]
- Yan, Y.; Yuan, Q.; Tang, J.; Huang, J.; Hsiang, T.; Wei, Y.; Zheng, L. Colletotrichum higginsianum as a Model for Understanding Host–Pathogen Interactions: A Review. Int. J. Mol. Sci. 2018, 19, 2142. [Google Scholar] [CrossRef]
- Guzmán, E.; Baeten, V.; Pierna, J.A.F.; García-Mesa, J.A. Determination of the olive maturity index of intact fruits using image analysis. J. Food Sci. Technol. 2015, 52, 1462–1470. [Google Scholar] [CrossRef]
- Schneider, C.A.; Rasband, W.S.; Eliceiri, K.W. NIH Image to ImageJ: 25 years of image analysis. Nat. Methods 2012, 9, 671–675. [Google Scholar] [CrossRef]
- Moral, J.; Trapero, A. Assessing the susceptibility of olive cultivars to anthracnose caused by Colletotrichum acutatum. Plant Dis. 2009, 93, 1028–1036. [Google Scholar] [CrossRef]
- Sharma, G.; Maymon, M.; Freeman, S. Epidemiology, pathology and identification of Colletotrichum including a novel species associated with avocado (Persea americana) anthracnose in Israel. Sci. Rep. 2017, 7, 15839. [Google Scholar] [CrossRef]
- Nifakos, K.; Tsalgatidou, P.C.; Thomloudi, E.-E.; Skagia, A.; Kotopoulis, D.; Baira, E.; Delis, C.; Papadimitriou, K.; Markellou, E.; Venieraki, A.; et al. Genomic Analysis and Secondary Metabolites Production of the Endophytic Bacillus velezensis Bvel1: A Biocontrol Agent against Botrytis cinerea Causing Bunch Rot in Post-Harvest Table Grapes. Plants 2021, 10, 1716. [Google Scholar] [CrossRef] [PubMed]
- Muñoz-Sabater, J.; Dutra, E.; Agustí-Panareda, A.; Albergel, C.; Arduini, G.; Balsamo, G.; Boussetta, S.; Choulga, M.; Harrigan, S.; Hersbach, H.; et al. ERA5-Land: A state-of-the-art global reanalysis dataset for land applications. Earth Syst. Sci. Data 2021, 13, 4349–4383. [Google Scholar] [CrossRef]
- R Core Team. A Language and Environment for Statistical Computing [WWW Document]. 2022. Available online: https://www.R-project.org/ (accessed on 7 July 2022).
- Wickham, H. The Tidyverse [WWW Document]. R package ver. 2017. Available online: https://www.tidyverse.org/ (accessed on 15 April 2023).
- Hijmans, R.J.; Bivand, R.; Forner, K.; Ooms, J.; Pebesma, E.; Sumner, M.D. Terra: Spatial Data Analysis [WWW Document]. 2022. Available online: https://CRAN.R-project.org/package=terra (accessed on 7 July 2022).
- Simes, R.J. An improved Bonferroni procedure for multiple tests of significance. Biometrika 1986, 73, 751–754. [Google Scholar] [CrossRef]
- Nawaz, H.H.; Manzoor, A.; Iqbal, M.Z.; Ansar, M.R.; Ali, M.; Kakar, K.M.; Awan, A.A.; Weiguo, M. Colletotrichum acutatum: Causal Agent of Olive Anthracnose Isolation, Characterization, and Fungicide Susceptibility Screening in Punjab, Pakistan. Plant Dis. 2023, 107, 1329–1342. [Google Scholar] [CrossRef]
- Talhinhas, P.; Baroncelli, R. Colletotrichum species and complexes: Geographic distribution, host range and conservation status. Fungal Divers. 2021, 110, 109–198. [Google Scholar] [CrossRef]
- Li, Q.; Bu, J.; Shu, J.; Yu, Z.; Tang, L.; Huang, S. Colletotrichum species associated with mango in southern China. Sci. Rep. 2019, 9, 18891. [Google Scholar] [CrossRef]
- Boddy, L.; Jones, T.H. Interactions between saprotrophic fungi and invertebrates in decomposing forest plant litter under climate change: Effects on fungal growth, reproduction, and community structure. Fungal Ecol. 2008, 1, 1–9. [Google Scholar] [CrossRef]
- Pautasso, M.; Döring, T.F.; Garbelotto, M.; Pellis, L.; Jeger, M.J. Impacts of climate change on plant diseases—Opinions and trends. Eur. J. Plant Pathol. 2012, 133, 295–313. [Google Scholar] [CrossRef]
- Correia, A.M.; Lira, S.P.; Assis, M.A.; Rodrigues, A. Fungal endophyte communities in Begonia species from the Brazilian Atlantic rainforest. Curr. Microbiol. 2018, 75, 441. [Google Scholar] [CrossRef]
- Vaz, A.B.M.; Fonseca, P.L.C.; Badotti, F. A multiscale study of fungal endophyte communities of the foliar endosphere of native rubber trees in Eastern Amazon. Sci. Rep. 2018, 8, 16151. [Google Scholar] [CrossRef]
- López-González, R.C.; Gómez-Cornelio, S.; Susana, C.; Garrido, E.; Oropeza-Mariano, O.; Heil, M.; Partida-Martínez, L.P. The age of lima bean leaves influences the richness and diversity of the endophytic fungal community, but not the antagonistic effect of endophytes against Colletotrichum lindemuthianum. Fungal Ecol. 2017, 26, 1–10. [Google Scholar] [CrossRef]
- Douanla-Meli, C.; Langer, E.; Mouafo, F.T. Fungal endophyte diversity and community patterns in healthy and yellowing leaves of Citrus limon. Fungal Ecol. 2013, 6, 212–222. [Google Scholar] [CrossRef]
- Fuentes-Aragon, D.; Silva-Rojas, H.V.; Guarnaccia, V.; Mora-Aguilera, J.A.; Aranda-Ocampo, S.; Bautista-Martinez, N.; Teliz-Ortiz, D. Colletotrichum species causing anthracnose on avocado fruit in Mexico: Current status. Plant Pathol. 2020, 69, 1513–1528. [Google Scholar] [CrossRef]
- Bonatelli, M.L.; Tsui, S.; Marcon, J.; Batista, B.D.; Kitajima, E.W.; Pereira, J.O.; Azevedo, J.L.; Quecine, M.C. Antagonistic activity of fungi from anthracnose lesions on Paullinia cupana against Colletotrichum sp. Plant Pathol. J. 2016, 98, 197–205. [Google Scholar]
- Zhang, Y.J.; Herrera-Balandrano, D.D.; Shi, X.C.; Wang, S.Y.; Laborda, P. Biocontrol of Colletotrichum brevisporum in soybean using a new genistein-producing Paecilomyces strain. Biol. Control. 2022, 169, 104877. [Google Scholar] [CrossRef]
- Alam, B.; Lǐ, J.; Gě, Q.; Khan, M.A.; Gōng, J.; Mehmood, S.; Yuán, Y.; Gǒng, W. Endophytic Fungi: From Symbiosis to Secondary Metabolite Communications or Vice Versa? Front. Plant Sci. 2021, 17, 791033. [Google Scholar] [CrossRef]
- Gadagkar, S.R.; Rosenberg, M.S.; Kumar, S. Inferring species phylogenies from multiple genes: Concatenated sequence tree versus consensus gene tree. J. Exp. Zool. B Mol. Dev. Evol. 2005, 304, 64–74. [Google Scholar] [CrossRef] [PubMed]
- Rivers, D.M.; Darwell, C.T.; Althoff, D.M. Phylogenetic analysis of RAD-seq data: Examining the influence of gene genealogy conflict on analysis of concatenated data. Cladistics 2016, 32, 672–681. [Google Scholar] [CrossRef]
- Braga, R.M.; Padilla, G.; Araújo, W.L. The biotechnological potential of Epicoccum spp.: Diversity of secondary metabolites. Crit. Rev. Microbiol. 2018, 44, 759–778. [Google Scholar] [CrossRef]
- Nzabanita, C.; Zhang, L.; Zhao, H.; Wang, Y.; Wang, Y.; Sun, M.; Wang, S.; Guo, L. Fungal endophyte Epicoccum nigrum 38L1 inhibits in vitro and in vivo the pathogenic fungus Fusarium graminearum. Biol. Control. 2022, 174, 105010. [Google Scholar] [CrossRef]
- McHenry, D.J.; Aćimović, S.G. New Species-Specific Real-Time PCR Assays for Colletotrichum Species Causing Bitter Rot of Apple. Microorganisms 2024, 12, 878. [Google Scholar] [CrossRef]
- He, J.; Sun, M.L.; Li, D.W.; Zhu, L.H.; Ye, J.R.; Huang, L. A real-time PCR for detection of pathogens of anthracnose on Chinese fir using TaqMan probe targeting ApMat gene. Pest. Manag. Sci. 2023, 79, 980–988. [Google Scholar] [CrossRef]
- Lahlali, R.; Taoussi, M.; Laasli, S.-E.; Gachara, G.R.; Ezzouggari Belabess, Z.; Aberkani, K.; Assouguem, A.; Meddich, A.; Jarroudi, M.E.; Barka, E.A. Effects of climate change on plant pathogens and host-pathogen interactions. Crop Environ. 2024, 3, 159–170. [Google Scholar] [CrossRef]
- Estrada, A.B.; Dodd, J.C.; Jeffries, P. Effect of humidity and temperature on conidial germination and appressorium development of two Philippine isolates of the mango anthracnose pathogen Colletotrichum gloeosporioides. Plant Pathol. 2001, 49, 608–618. [Google Scholar] [CrossRef]

| Isolated from Olive Fruits | Isolated from Olive Leaves | ||
|---|---|---|---|
| Isolate Code (GenBank Acc. No.) | Identity to the Closest Species (GenBank Acc. No.) | Isolate Code (GenBank Acc. No.) | Identity to the Closest Species (GenBank Acc. No.) |
| KOR5f (OR146582) | 99.57% Colletotrichum acutatum (EU727318.1) | KOR9l (OR146583) | 99.14% C. acutatum (FN566876.1) |
| KOR7f (OR146599) | 100% C. acutatum (EF622200.1) | KOR12l (OR146592 | 100% C. acutatum (EF622201.1) |
| KOR10f (OR146586_ | 100% C. acutatum (EF622201.1) | KOR15l (OR146584 | 100% C. nymphaeae (KP606646.1) |
| KOR16f (OR146587) | 100% C. scovillei (MF629912.1) | KOR19l (OR146585 | 99.63 C. scovillei (ON961752.1) |
| KOR17f (OR146602) | 100% C. scovillei (MF629911.1) | KOR40l (OR146601 | 100% C. acutatum (EF622201.1) |
| KOR20f (OR146588) | 100% C. scovillei (MF629914.1) | KOR43l (OR146594 | 100% C. acutatum (KM594097.1) |
| KOR21f (OR146597) | 100% C. acutatum (ON962736.1) | K0R48l (OR146598 | 99.81% C. acutatum (JN121184.1) |
| KOR23f (OR146600) | 99.44% C. scovillei (MF629906.1) | KOR44l (OR230695 | 100% Alternaria zp. (MG025872.1) |
| KOR38f (OR146593) | 99.45% C. acutatum (EF622200.1) | KOR37l (OR230693 | 100% Epicoccum sp. (MT626569.1) |
| KOR45f (OR146596) | 99.45 C. acutatum (MF629920.1) | KOR34l (OR230694 | 100% Fusarium sp. (KJ598867.1) |
| KPO46f (OR230682) | 99.62% Fusarium sp.(MW016692.1) | KOR33l (OR230688) | 100% Fusarium sp. (MF919404.1) |
| KOR42f ( OR230687) | 100% Fusarium sp. (MT090005.1) | KOR27l (PQ035222) | 98.89% Epicoccum sp. (KR912314.1) |
| KOR41f (OR230680) | 100% Fusarium sp. (MT134967.1) | KOR18l (OR230697) | 100% Nigrospora sp. (KP900301.1) |
| KOR25f (OR230686) | 100% Fusarium sp (MK508845.1) | KOR3l (PQ035132) | 100% Epicoccum sp. (KP749197.1) |
| KOR11f (OR230684) | 98.79% Fusarium sp. (MT558582.1) | KOR2l (PQ035131) | 100% Alternaria sp. (MH487275.1) |
| KOR6f (OR230681) | 99.63% Altenaria sp. (MW009021.1) | KOR1l (PQ035130) | 100% Epicoccum sp. (KR912314.1) |
| KOR39f (OR230685) | 100% Fusarium sp. (MK102639.1) | ||
| KOR14f (OR2306830 | 100% Fusarium sp. (MK248478.1) | ||
| KOR13f (OR230691) | 100% Talaromyces sp. (KJ775705.1) | ||
| KOR4f (OR230696) | 98.37% Fusarium sp. (MT567303.1) | ||
| KOR8f (OR230692) | 93.57% Epicoccum sp. (MT355641.1) | ||
| KORD1f (OR230690) | 99.66% Phlebia sp. (MT458525.1) | ||
| KORD4f (OR230689) | 92.91% Epicoccum sp. (LC543646) | ||
Disclaimer/Publisher’s Note: The statements, opinions and data contained in all publications are solely those of the individual author(s) and contributor(s) and not of MDPI and/or the editor(s). MDPI and/or the editor(s) disclaim responsibility for any injury to people or property resulting from any ideas, methods, instructions or products referred to in the content. |
© 2025 by the authors. Licensee MDPI, Basel, Switzerland. This article is an open access article distributed under the terms and conditions of the Creative Commons Attribution (CC BY) license (https://creativecommons.org/licenses/by/4.0/).
Share and Cite
Nifakos, K.; Tsalgatidou, P.C.; Tsafouros, A.; Angeli, C.; Kartsonas, E.; Delis, C.; Charalampopoulos, I.; Venieraki, A.; Katinakis, P. Colletotrichum scovillei and Prospective Biocontrol Agents Isolated from Asymptomatic Olive Trees. Microorganisms 2025, 13, 2838. https://doi.org/10.3390/microorganisms13122838
Nifakos K, Tsalgatidou PC, Tsafouros A, Angeli C, Kartsonas E, Delis C, Charalampopoulos I, Venieraki A, Katinakis P. Colletotrichum scovillei and Prospective Biocontrol Agents Isolated from Asymptomatic Olive Trees. Microorganisms. 2025; 13(12):2838. https://doi.org/10.3390/microorganisms13122838
Chicago/Turabian StyleNifakos, Kallimachos, Polina C. Tsalgatidou, Athanasios Tsafouros, Christina Angeli, Epaminondas Kartsonas, Costas Delis, Ioannis Charalampopoulos, Anastasia Venieraki, and Panagiotis Katinakis. 2025. "Colletotrichum scovillei and Prospective Biocontrol Agents Isolated from Asymptomatic Olive Trees" Microorganisms 13, no. 12: 2838. https://doi.org/10.3390/microorganisms13122838
APA StyleNifakos, K., Tsalgatidou, P. C., Tsafouros, A., Angeli, C., Kartsonas, E., Delis, C., Charalampopoulos, I., Venieraki, A., & Katinakis, P. (2025). Colletotrichum scovillei and Prospective Biocontrol Agents Isolated from Asymptomatic Olive Trees. Microorganisms, 13(12), 2838. https://doi.org/10.3390/microorganisms13122838










